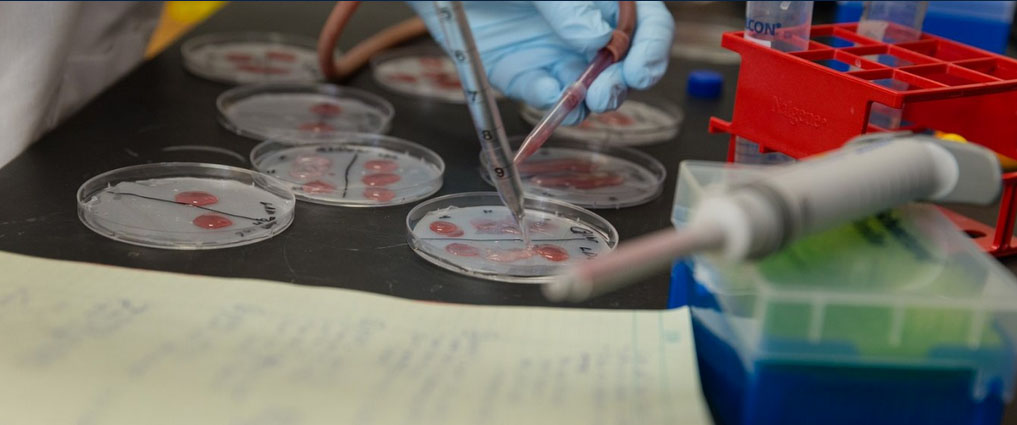

| |
Apr 16, 2026
|
|
|
|
|
2025-2026 Graduate Catalog
Biological Sciences (M.S.) - Biology Specialization
|
|
Return to: Colleges, Departments, Schools and their Academic Programs
%20-%20Biology%20Specialization.png)
Program Coordinator/Contact
Jeremy Chambers, Department Head
Radhey Kaushik, Professor and Graduate Coordinator
Department of Biology and Microbiology
Alfred Dairy Science Hall 228, Box 2104A
605-688-6141
Program Information
The Department of Biology and Microbiology provides students with a wide range of opportunities for advanced study. The graduate faculty offer expertise and graduate student advisement in subdisciplines from molecular biology through ecology. Faculty members are very successful in obtaining extramural funds to support graduate student projects. Graduate students have modern research laboratories, equipment and field research sites available to carry out their research projects. The learning environment, scholarly excellence and quality of teaching are areas of strength in the department’s Graduate Program.
Course Delivery Format
Biological Sciences courses are delivered face-to-face and enhanced with web-based instruction. Online delivery may be offered for specific courses.
|
Available Options for Graduate Degrees
| Master of Science | Thesis | 30 Credit Hours | | | Non-Thesis | 32 Credit Hours | Core Requirements
For details see specific program: Biological Sciences (M.S.) The student, major advisor and Advisory Committee select the discipline specific emphasis area of the biological sciences. The courses will be identified on the student’s Plan of Study no later than the end of the first year of study. Thesis
- XXX 790 - Seminar Credits: 2
- XXX 798 - Thesis Credits: 5-10
- 3 or more credits of STAT courses numbered 500-level or higher
- 6 additional course credits, designed to meet the interests and individual needs of the student
- Electives Credits: 9-14
Non-Thesis
- XXX 790 - Seminar Credits: 2
- XXX 788 - Research Problems/Project minimum Credits: 2-3
- 3 or more credits of STAT courses numbered 500-level or higher
- Electives Credits: 18-19
Total Required Credits: 30 (Thesis), 32 (Non-Thesis)
Master’s Graduation Requirements
- Yearly evaluation (research progress + coursework)
- Presentation of Thesis/Paper (public) during last semester of program
- Oral defense of Thesis (committee) during last semester of program
- Thesis (Plan A) - OR - Research Paper (Plan B) completion
Additional Admission Requirements
GRE: Scores ranking above the 50th percentile will strengthen the case for admission TOEFL: 90 Internet-based TOEFL Essentials: 9.5 IELTS: 6.5 Duolingo: 115 At least two letters of reference or Personal References must be sent to the Department. A personal statement that includes a description of the applicants involvement in research, the applicants research interest, and career goals is also required. Retention in the program is dependent on formation of a committee and completion of review matrix by the end of the first year. In ensuing years, students must have a committee meeting and complete review annually. General Requirements
Graduate students should consult with their advisor before registering for graduate coursework. For additional information, refer to the Master’s Degree Requirements . |
Return to: Colleges, Departments, Schools and their Academic Programs
|
|